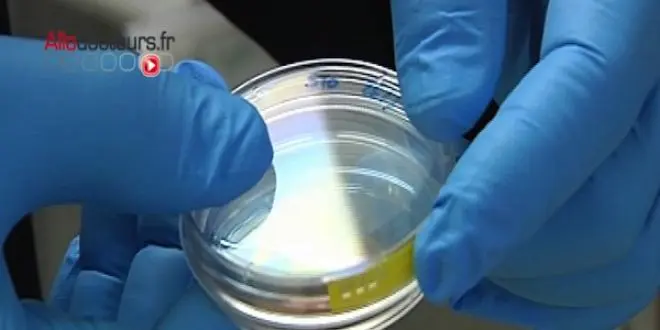

La recherche sur l'embryon autorisée en France
Le Parlement a définitivement adopté ce mardi 15 juillet 2013, par un vote des députés, le texte autorisant la recherche sur l'embryon et les cellules souches, soutenu par le gouvernement pour que la France rattrape son "retard". Cette proposition de loi des radicaux de gauche a été adoptée par 314 voix contre 223.
Par La rédaction d'Allo Docteurs
Rédigé le
La recherche sur l'embryon et les cellules souches passe en France ainsi de l'interdiction avec dérogations, en vigueur depuis 2004, à l'autorisation encadrée. Cette interdiction avait été renouvelée lors des révisions de loi bioéthique en 2011, à l'issue de débats enflammés.
Les députés ont dû s'y reprendre à deux fois pour examiner cette proposition de loi PRG, adoptée par le Sénat en décembre 2012. Fin mars en effet, des députés UMP avait torpillé le texte à force d'obstruction.
"L'enjeu, c'est la médecine régénérative et la thérapie cellulaire", a expliqué le président des députés PRG, Roger-Gérard Schwartzenberg, ancien ministre de la Recherche.
"Dans quelques instants, pensez à ceux de nos concitoyens malades qui attendent, qui espèrent des thérapies nouvelles", a-t-il ajouté, citant la dégénérescence de la rétine, la maladie d'Alzheimer, ou encore les maladies cardiaques. Comme la ministre de la Recherche Geneviève Fioraso avant lui, il s'est fait fort de rappeler qu'un certain nombre de ténors UMP comme François Fillon, Alain Juppé, Nicolas Sarkozy, ou centristes comme Jean-Louis Borloo, avaient voté en faveur de l'autorisation en janvier 2002. Le projet n'était pas allé à son terme du fait des élections.
Ancien rapporteur des lois de révisions bioéthiques, Jean Leonetti (UMP) s'est inscrit en faux : "Oui, en été, en session extraordinaire, nous avons bâclé un débat", a-t-il lancé, affirmant que la recherche n'était pas entravée par le régime actuel. Il a mis en garde contre "les espoirs déçus" : "Ne laissez pas croire que les gens seront guéris". "L'éthique doit-elle changer quand la majorité change ?", a-t-il demandé.
"Une avancée que nous attendons depuis 35 ans"
Jean-Christophe Fromantin (UDI) a fustigé un texte qui n'est "pas assumé politiquement". Des députés UMP ont dit regretter que ce texte ait pris la forme d'une proposition de loi (d'origine parlementaire), au lieu d'être présenté par le gouvernement.
"Quel grand jour pour la bioéthique !", s'est exclamé de son côté le député PS Jean-Louis Touraine. C'est une "avancée que nous attendons depuis 35 ans", a-t-il ajouté, jugeant que l'accusation portée par l'UMP d'une loi adoptée en catimini au coeur de l'été était une "calomnie" alors que "le débat a duré 30 ans". Il a critiqué les "opposants au progrès".
Jacqueline Fraysse (Front de Gauche) a, elle, mis en avant les "freins" actuels à la recherche du fait des recours intentés par la Fondation Lejeune qui soutient la recherche sur la trisomie et la lutte contre l'avortement. Le régime actuel "instaure un climat délétère", a renchéri Véronique Massonneau (écologiste).
La semaine dernière, le débat s'est déroulé dans un hémicycle quasi vide, avec quelques députés UMP qui étaient déjà beaucoup intervenus en 2011 et aussi pendant le projet de loi autorisant le mariage homosexuel, comme Marc Le Fur ou Philippe Gosselin.
"Un quarteron de parlementaires UMP a essayé de transformer ce débat en deuxième tour du mariage pour tous en privilégiant des positions idéologiques très dures, parfois complètement surréalistes, alors qu'il s'agit de faire avancer non plus seulement la recherche mais aussi les essais thérapeutiques", a affirmé mardi Thierry Mandon, porte-parole des députés PS.
Selon le dernier bilan de l'Agence de biomédecine, qui décide des dérogations, 70 projets ont été autorisés depuis 2005.
En savoir plus
Sur Allodocteurs.fr :










